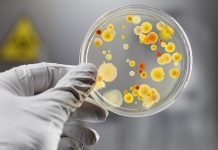
Епідеміологи застерігають: літо — сезон гострих кишкових інфекцій

ДТЕК Павлоградвугілля добув 10 млн т. вугілля до 10-річчя компанії
На початку липня компанії ДТЕК виповнилося 10 років, а 10 липня гірники ДТЕК Павлоградвугілля добули 10 млн т. вугілля. За всю історію Павлоградвугілля це...
На свято Івана Купала хлопчик отримав опік
В ніч з 7 на 8 липня у Павлоградському районі стався нещасний випадок. Хлопчик Микита, 2003 року народження, отримав серйозний опік під час перестрибування...
У Павлограді горів склад магазину техніки
У Павлограді горів склад магазину технікиВчора близько 12 години дня виникла пожежа у складі магазину техніки «Фокстрот». Склад знаходиться на вул. Шевченка, у дворі...
Художниця, яка народилася у Павлограді, презентувала виставку у Львові
У художній галереї «Дзига» м. Львова відкрилася виставка херсонської художниці наївного жанру Олени Рибальченко. Про це повідомляє сайт «Вголос».
«Олена народилася в Павлограді. Більше 30...
Епідеміологи застерігають: літо — сезон гострих кишкових інфекцій
Влітку починають діяти численні сезонні фактори, які сприяють зараженню гострими кишковими інфекціями. Про це попереджає лікар-епідеміолог павлоградської спеціалізованої медсанчастини № 7 Юлія Невородчук.До інфекційних...
Сьогодні на Дніпропетровщині стартувала вступна кампанія
Сьогодні 78 вишів Дніпропетровської області розпочали прийом документів від вступників. Кампанія триватиме до 31 липня. Про це під час прес-конференції повідомила начальник відділу науки та...
Міжнародна спільнота передала у Павлоград гуманітарну допомогу
Більше 200 комплектів з гуманітарною допомогою для сімей вимушених переселенців передала до Павлограду міжнародна спільнота.Зараз комплекти розвантажені павлоградськими рятувальниками у будинку культури ім. Кірова....
Підприємства, які мали ремонтувати павлоградський театр, оштрафував Антимонопольний комітет
ТОВ «СМУ-21» та ТОВ «БУД-ПІК» порушили законодавство про захист економічної конкуренції, коли брали участь у тендері на ремонт «Павлоградського драматичного театру імені Б.Є. Захави»....
Рятувальникам довелося визволяти жінку із полону… дивану
Вчора на вул. Миру в м. Тернівка працівникам пожежно-рятувального відділення 50 ДПРЧ Головного управління ДСНС України у Дніпропетровській області довелося через вікно проникати у...
Лише 4 села Павлоградщини мають придатне асфальтове покриття
З 13 сільських рад Павлоградщини лише 4 мають придатне асфальтове покриття. Про це розповів голова Павлоградської райдержадміністрації Святослав Максимчук.
«Вперше за всю історію нам виділили...